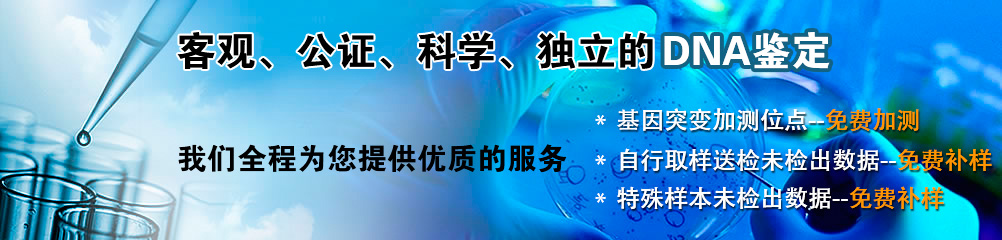
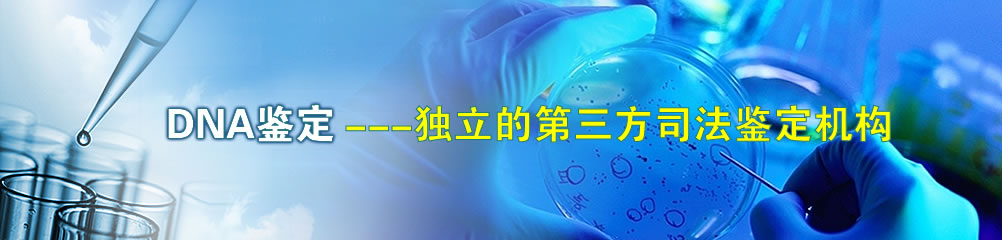

全国上门取样服务,预约电话:400-652-0127,020-38077560。加急48小时能出结果,为您尽快解决烦恼。
|
|
本检测中心与广东一粤律师事务所律师、司法部部级文明律师事务所合作,保证亲子鉴定程序正规化、结果准确化、效力合法化。为客户提供免费的法律支持。 |
|
我们的国际司法亲子鉴定和国内司法亲子鉴定程序标准化,建立了详细的客户数据、正规的司法亲子鉴定程序、报告和严格的文档保管程序,使亲子鉴定结果成为权威的证据呈现于国际司法事务和国内法庭之上。 |